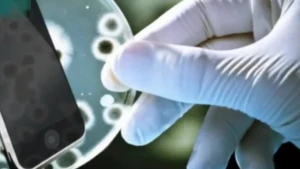

Kategoriler
UYGULAMALAR
İstanbul

Pek çok insan tuvalete girerken cep telefonunu da yanında götürüyor. Sosyal medyada gezinmek, oyun oynamak ya da mesajlara bakmak tuvalete girerken daha bir hoş geliyor. Ancak yapılan araştırmalar bu alışkanlığın pek masum olmadığını gösteriyor. Peki telefonla tuvalete girmek neden tehlikeli? İşte duyunca çok şaşıracağınız detaylar...
Tuvalete girme alışkanlığı sadece hijyen bakımından değil, vücut sağlığı açısından da oldukça kritik. Bizim göremediğimiz bakteriler tuvalet ortamında telefonun üzerinde birikirken, uzun süre oturunca sindirim sitemi de bu durumdan etkileniyor.

Uzmanlar havaya karışan bakterilerin tuvalette çok daha kolay telefona yapışabiliyor. Sifonu çeker çekmez ise E. coli denilen tehlikeli bakteriler bir anda etrafa yayılıyor. Elimize aldığımız telefonlar ise bu bakterileri bir mıknatıs gibi çekiyor. Tuvaletten çıktığımızda bizimle beraber gelen mikroplar evin her yanına bu şekilde bulaşabiliyor. Özellikle çocuklu evlerde durum çok daha riskli olabiliyor.
Telefonla tuvalete girmek sadece mikropları evin her köşesine taşımakla kalmıyor aynı zamanda ciddi sağlık riskleri de oluşturuyor. Hepimiz biliyoruz ki, telefonla tuvalete girince geçirilen zaman daha da uzuyor. Bu durum oturulan zamanın uzamasıyla bağsura resmen davetiye çıkarıyor. Bununla birlikte maruz kalınan ekran ışığı ve odaklanma da bağırsak hareketlerini yavaşlatıyor. Sadece birkaç dakikalık keyif, kabızlığa da neden oluyor.

Telefonla tuvalete girmenin zararlı etkileri saymakla bitmiyor. Sadece fiziksel zararları olduğunu düşünüyorsanız yanılıyorsunuz. Bu alışkanlık psikolojik bir bağımlılığın da göstergesi adeta. Tuvalete bile giderken, yanına telefonunu götürenlerin teknolojik bağımlılığı giderek artıyor. Farkına bile varılmayan bu durum psikolojik olarak kişiyi etkiliyor.

Peki telefonu tuvalete götürme alışkanlığının oluşturduğu zararlardan korunmak için ne yapılması gerekiyor? İşte size basit ama oldukça etkili birkaç yöntem...



Sifon sonrası havaya yayılan bakteriler telefon yüzeyine yapışır ve kolayca taşınır. Bu durumda telefonla tuvalete girdiğinizde mikropları telefonunuzda taşımış olursunuz.
Hemen hasta olmayabilirsiniz. Ancak bakterilerin birikmesi sonucu zamanla enfeksiyon riskini artar ve hasta olmanızı daha kolaylaştırır.

Alkol bazlı mendiller ya da özel ekran temizleyicilerle düzenli olarak silmek telefon temizliğinde en güvenli ve en etkili yöntem olarak öne çıkar.
Tuvalete telefonla girince oturma süresini uzar ve bu durum bağırsak sağlığını bozabilir. Ayrıca bu alışkanlık hemoroid riskini yükseltir.
Kesinlikle. Telefonu tuvalette bile elden bırakmamak teknoloji bağımlılığının ilerlemesine neden olur.